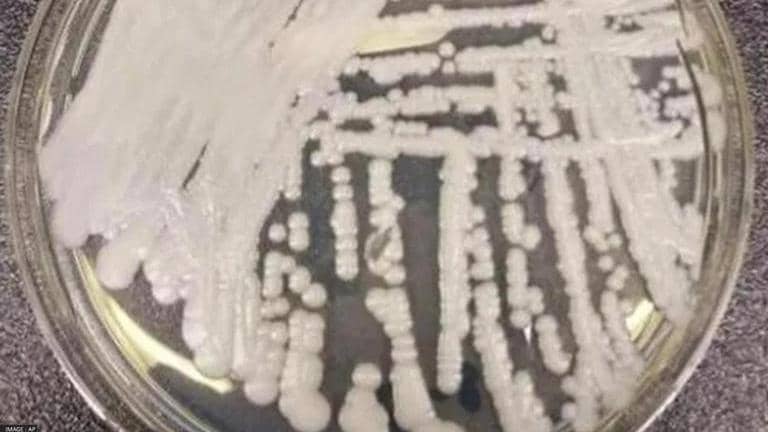

US witnesses drug resistant deadly fungal infection that's spreading at alarming rate: CDC
Fungus Candida Auris is found in more than 30 countries but was first reported in US in 2016. Until 2021, there have been an estimated 3,270 cases on record.
- World News
- 2 min read
The US is witnessing the spread of a deadly drug-resistant and what is being described as a potentially "deadly fungus" that is causing infection among Americans at an alarming rate, researchers from the Centers for Disease Control and Prevention stated on Tuesday, according to American broadcasters. The fungus behind the spread is a type of yeast called Candida Auris, or C. Auris, and it can reportedly cause "severe illness" among people who have a weakened immune system. According to CDC, scores of people have been found diagnosed with C. Auris and are now infected. CDC's findings have been published in the Annals of Internal Medicine and the warnings come as the Mississippi Department of Health is battling a major outbreak of the fungus across the state.
'Sudden spike concerning to us': CDC
The sudden spike in the cases of infection “especially in the most recent years is really concerning to us,” CDC's study author, Dr Meghan Lyman, a chief medical officer in the CDC’s Mycotic Diseases Branch, told NBC news. “We’ve seen increases not just in areas of ongoing transmission, but also in new areas," she added. The fungus infection, which is also resistant to antifungal medication, according to American healthcare experts, has now turned into a "dangerous public healthcare threat." Doctors in the US are warning that the deadly fungus infection might lead to serious illness as well as fatalities. Those at risk the most are the vulnerable groups that use or have used invasive medical devices in healthcare facilities. As many as 30% to 60% of those infected died from the illness, last year.
Fungus Candida Auris is found in more than 30 countries but was first reported in the US in 2016. Until 2021, there have been an estimated 3,270 cases of infections on record of a total of 7,413 screenings, the CDC noted. The infection can spread from bodily contact, person to person, as well as from contaminated surfaces due to a lack of hygiene. There aren't many known control methods that have proven to be effective to fight the disease, according to the CDC findings. The infected patient can be identified via a test of the bodily fluids.
